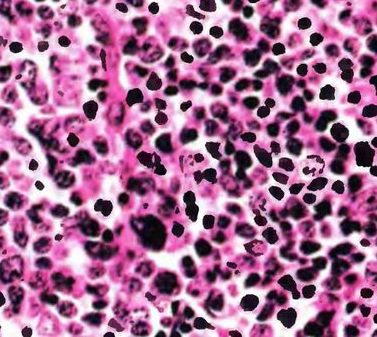
11.jpg
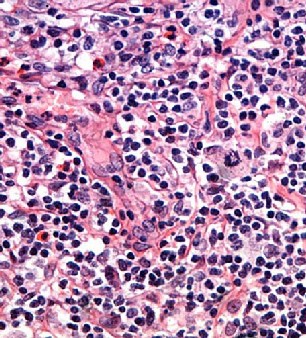

Каждый год 15 сентября проводится Международный день борьбы с лимфомами. Празднуется в России, Беларуси, Украине и других странах. Общество больных лимфомами создано в сентябре 2003 года в Европе. В 2016 году насчитывается более 7 тысяч членов, проживающих на разных континентах нашей планеты.
Основными целями программы является увеличение осведомленности общественности о лимфоме, о проявлениях болезни, увеличение ранней выявляемости заболевания. Поэтому важнейшей задачей государства и социально ответственных организаций врачи считают необходимость просвещения населения в связи с появлением новейших средств борьбы с лимфомами.
Лимфома — злокачественная опухоль из клеток иммунной системы, которая поражает лимфатическую систему, состоящую из костного мозга, вилочковой железы, селезёнки и лимфатических узлов
Первые симптомы лимфом — увеличение размеров лимфатических узлов разных групп (шейных, подмышечных или паховых). Лимфомы представляют собой группу более чем из 30 заболеваний, которыми может заболеть человек любого возраста: от раннего детства до глубокой старости. Заболеваемость в Европе составляет 15 случаев на 100 тыс. населения в год. В России каждый год выявляется свыше 10тыс. новых случаев заболеваемости лимфомой. Это 4% от всех раковых патологий.
Шансы больных на выздоровление полностью зависят от точной и своевременной диагностики заболевания. При своевременном выявлении и качественной терапии, лимфома излечима в 80% случаев, а нынешние технологии позволяют полностью излечивать или существенно улучшать качество жизни больных лимфомой.